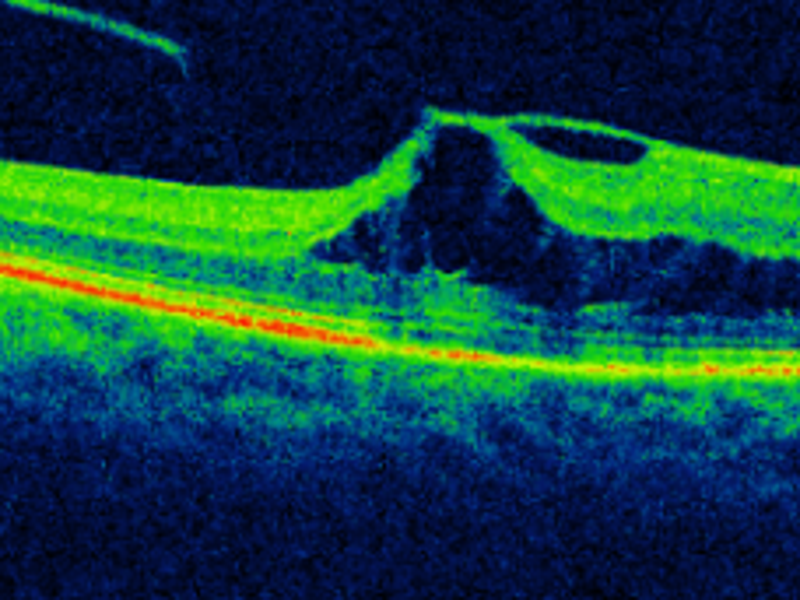

Ihr Augenarzt in Schwanenstadt


Terminvereinbarung:
Tel. 0664 7350 8528
Ich bin spezialisiert auf Lidchirurgie, Netzhautchirurgie, Kataraktchirurgie und Kinderaugenheilkunde. Mit 20 Jahren Erfahrung als Oberarzt an verschiedenen Abteilungen bin ich stolz darauf, hochqualitative Augenheilkunde anzubieten.
Meine Leistungen
Dr. Ernst Dragosits ist ein erfahrener Ophthalmologe mit einer Leidenschaft für Kinderaugenheilkunde, Lidchirurgie, Netzhautchirurgie und Kataraktchirurgie. Seine Ausbildung an der Universitätsklinik Innsbruck und 20 Jahre als Oberarzt haben ihn zu einem Experten auf seinem Gebiet gemacht.
Vereinbaren Sie noch heute einen Termin unter 0664 7350 8528
Erhalten Sie die bestmögliche Augenheilkunde von einem erfahrenen und engagierten Team. Kontaktieren Sie uns, um einen Termin zu vereinbaren und Ihre Sehprobleme zu lösen.